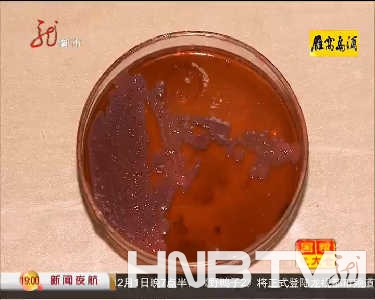
点击浏览下一页

哈尔滨市民直接用手拿免费品尝的熟食品。(图像来自视频截图)
一些在超市和路边摊买的熟食被检查出来有大量超标的大肠杆菌。(图像来自视频截图)
黑龙江网络广播电视台讯 据龙视都市频道《新闻夜航》栏目报道 熟食,作为我们生活中重要的即食食品一直受到大家的喜爱,从最初的烤鸡,肘子,猪头肉,到现在的鸭头,鸭脖儿,等等,不知道您吃怎么样,我是吃坏过肚子,这些东西到底干净不呢?……
近年来,食品安全问题越来越成为大家所关注的话题。然而多地爆出的超市熟食不合格,散装熟食合格率不足四成,熟食防腐剂超标,熟食食用后腹泻等新闻让人异常担心熟食的安全。今年9月份,央视更是爆出多家知名熟食店食品的细菌严重超标,有的甚至超过了仪器的最高值。种种事件这让我们不禁怀疑,经常吃的熟食到底安全吗?
图方便,很多人会选择在夜市以及市场就近购买熟食,而到了炎热的夏季,没有了冷藏设备,各家知名熟食店和大超市则成为了大家的首选,哪天做的?干净吗?成为了大家购买熟食前出现频率最多的问话。
当然,您得到的回答百分之百是肯定的,这个时候,在您心中会不会再问上一句,他说的这些是真的吗?为了了解真相,我们分别调查了哈尔滨市内的几家知名熟食店、超市以及路边摊。看看这些熟食的卫生情况到底怎么样。
在哈尔滨几家超市里,不少熟食区的柜台都敞着口,看很多熟食已经放置了很长时间,而在熟食柜台前,大多都会有一个试吃的盘子。
想必两位在超市里也没少看没少摸了,这逛久了累了、饿了,看到色香味俱全的熟食怎能抵挡住诱惑呢。
对于熟食的卫生情况,老板信誓旦旦,并保证保鲜膜封上放在冰柜里放上三天绝对没问题。这不管怎么说也算有措施,不过这家就有点儿……
在哈尔滨犁华小区旁的夜市,熟食商品一应俱全,可卫生情况却让人不敢苟同。您瞧这位,直接上手就抓,而且指甲里还有明显的黑泥,倒不是嫌乎您。可那毕竟是我们往嘴里放的食物啊。
寒冷的天气代替了冷藏设备,真皮触摸代替一次性手套,迎着风,就着口水,显然,这样的熟食不太受欢迎。
家家都保证自己的熟食新鲜出炉,干干净净, 我们购买了超市,熟食店,街边摊的九份熟食样本,送到了哈尔滨商业大学食品工程学院的化学实验室,做大肠杆菌的检测。这些食物真的干净吗?最专业的检测将告诉你结果。
检测结果显示,我们送去的七份样本中,商委红肠、哈肉联红肠、一手店宣庆街店的肉丸以及家乐福太平桥店奥尔良翅根的大肠菌群MPN值均小于三十,符合国家标准。然而剩下的三份熟食却让人大跌眼镜,其中在哈尔滨黎华小区夜市熟食摊位购买的灌肠 大肠菌群每百克的MPN数值为72,沃尔玛超市十字街店奥尔良翅根的数值为2400,同为沃尔玛超市十字街店的试吃红肠数值竟然大于11000。
哈尔滨商业大学 食品工程学院:九管法都是产酸产气,大于11000,那就是顶级了,就是最多的了。
哈尔滨市质量技术监督局 微生物:遵循的是国家强制性的熟肉制品的卫生标准,它的标准代号是GB2726——2005,肉灌制品大肠菌群小于等于30,熏制类的大肠菌群是小于等于90,像酱牛肉、酱猪爪大肠菌群小于等于150,它到底是合格产品还是不合格产品,我们都按照这个标准来判定.
这么看来,在夜市购买的灌肠大肠菌群是国家标准两倍之多,沃尔玛超市的奥尔良翅根大肠菌群则是国家标准的近27倍,而沃尔玛超市提供给顾客的试吃红肠,大肠菌群竟然达到了国家标准的366倍!!!
如此惊人的数字不仅让人猜想,这些熟食店在制作和运输中究竟是怎样做的,为什么会有超标如此严重的现象呢?
商家依然信誓旦旦,我们同样把两份熟食送到哈尔滨商业大学食品工程学院化学实验室检验大肠杆菌,最终得到的结果同样惊人。绝味鸭脖宣庆街店的大肠菌群MPN数值为230,是国家标准的1.5倍。而久久鸭宣庆街店的鸭脖则超过了国标中检测大肠菌群的最大值,也就是大于11000,达到了国家标准的73倍以上。
哈尔滨商业大学 食品工程学院 高级工程师 王金凤:就在运输的过程中,和销售的过程中,因为运输过程中的箱子,它不经常消毒,往地上放,因为地上好多粪便污染了,因为肉眼是看不到的,所以可能就染上了,在卖的时候,由于销售人员,不经常消毒、洗手,或者他上卫生间,回来不洗手谁也不知道,这个过程中就可能染上了。

